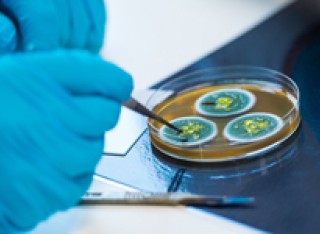
Gloved hands with a petri dish

Research themes
Our ambition is to become a leading global university performing impactful research and innovation and achieving outcomes which make important contributions to society.
Find out about the research areas we are focusing on from a global level to faculty-specific priorities, which is underpinned by our strategy.
Strategic research themes
Our research themes allow us to build on our existing strengths and invest in new complementary areas where we can demonstrate a distinctive capability.
Cross-collaboration health research

Pan-University institutes
The primary purpose of these pan-University institutes is to support the University's aspirations for increasing the scale and enhancing the excellence of our research and innovation.
Faculty research themes
At the heart of all our research at Surrey, our three faculties are focused on the following specific areas.
Faculty of Arts and Social Sciences
- Living and Working in the Digital Age
- Society, Economy and Sustainability
- Innovative Methodologies
- Crime, Security, and Justice
- Inequalities, Governance, and Wellbeing
- Cultural Practices
Faculty of Engineering and Physical Sciences
- Connected systems
- Future electronics
- Communication technologies
- Computational fluid dynamics and environmental flow
- Visual and audio analysis
- Nuclear science
- Made-to-measure materials
- Sustainability, environment and resilience
- Engineering for health
- Space and aerospace
Faculty of Health and Medical Sciences
- Chronobiology and sleep
- Digital health and data science
- Educational research
- Healthy ageing and supporting long-term conditions
- Individuals, organisations and society
- Infection and immunity
- Nutrition and food security